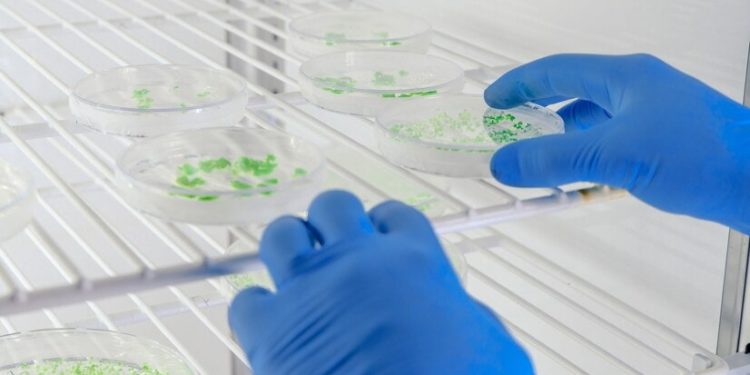
Proteína cultivada no Brasil: JBS e UFSC firmam acordo para impulsionar pesquisas

Proteína cultivada no Brasil terá cessão de instalações do JBS Biotech Innovation Center
A JBS e a Universidade Federal de Santa Catarina (UFSC) assinaram na segunda-feira (20), um memorando de entendimento para cooperação mútua em estudos e pesquisas sobre proteína cultivada no Brasil.
O acordo prevê a cessão de instalações do JBS Biotech Innovation Center, primeiro Centro de Pesquisa, Desenvolvimento e Inovação em proteína cultivada do país, para a execução dos trabalhos científicos.
Proteína cultivada no Brasil
O acordo de proteína cultivada no Brasil é o primeiro de muitos que o JBS Biotech Innovation Center prepara e tem como objetivo acelerar o avanço da indústria nacional no setor.
“A tecnologia da proteína cultivada tem se provado relevante para o mundo e a JBS não poderia deixar de estar na vanguarda”, afirmou o CEO Global da JBS, Gilberto Tomazoni.
“Estamos felizes com esta oportunidade de cooperar com iniciativas público-privadas como esta. Todo mundo ganha e geramos conhecimento”, completou.
Já para o reitor da UFSC, Irineu Manoel de Souza, a parceria com a JBS é importante para o desenvolvimento científico e tecnológico do país.
“Juntamente com a JBS vamos produzir pesquisas, pensando na qualidade de vida das pessoas”, disse.
“Um protocolo dessa natureza pode acrescentar com propostas e mudanças nas disciplinas dos cursos, começando por uma disciplina optativa e depois até gerar atualizações no currículo de toda a universidade”.
Localização
O JBS Biotech Innovation Center fica em Florianópolis e deve ser concluído em 2024.
O projeto receberá quase US$ 62 milhões de investimentos e contará com uma equipe científica de 25 pós-doutores, além de staff e equipe de apoio administrativo.
Atualmente, a JBS também desenvolve pesquisas em proteína cultivada na Espanha, onde é acionista controladora da Biotech Foods, empresa líder europeia no setor.
Sobre a proteína cultivada
A proteína cultivada é produzida a partir de células animais cultivadas em laboratório, sem a necessidade de abate de animais.
Além disso, essa tecnologia possui o potencial de reduzir o impacto ambiental da produção de proteína animal, e ainda oferece uma alternativa mais sustentável e ética para os consumidores.
Quando estiver em fase comercial, a proteína cultivada a ser processada pela JBS deve chegar aos consumidores na forma de alimentos preparados, como hambúrgueres e almôndegas, entre outros, com a mesma qualidade, sabor e textura da proteína tradicional.
Por fim, os investimentos na tecnologia indicam potencial não apenas para a produção de proteína bovina, mas também de frangos, suínos e pescados.
*Foto: Reprodução/br.freepik.com/fotos-gratis/tecnico-de-laboratorio-que-examina-uma-substancia-em-placas-de-petri-enquanto-realiza-pesquisas-sobre-coronavirus_7678088